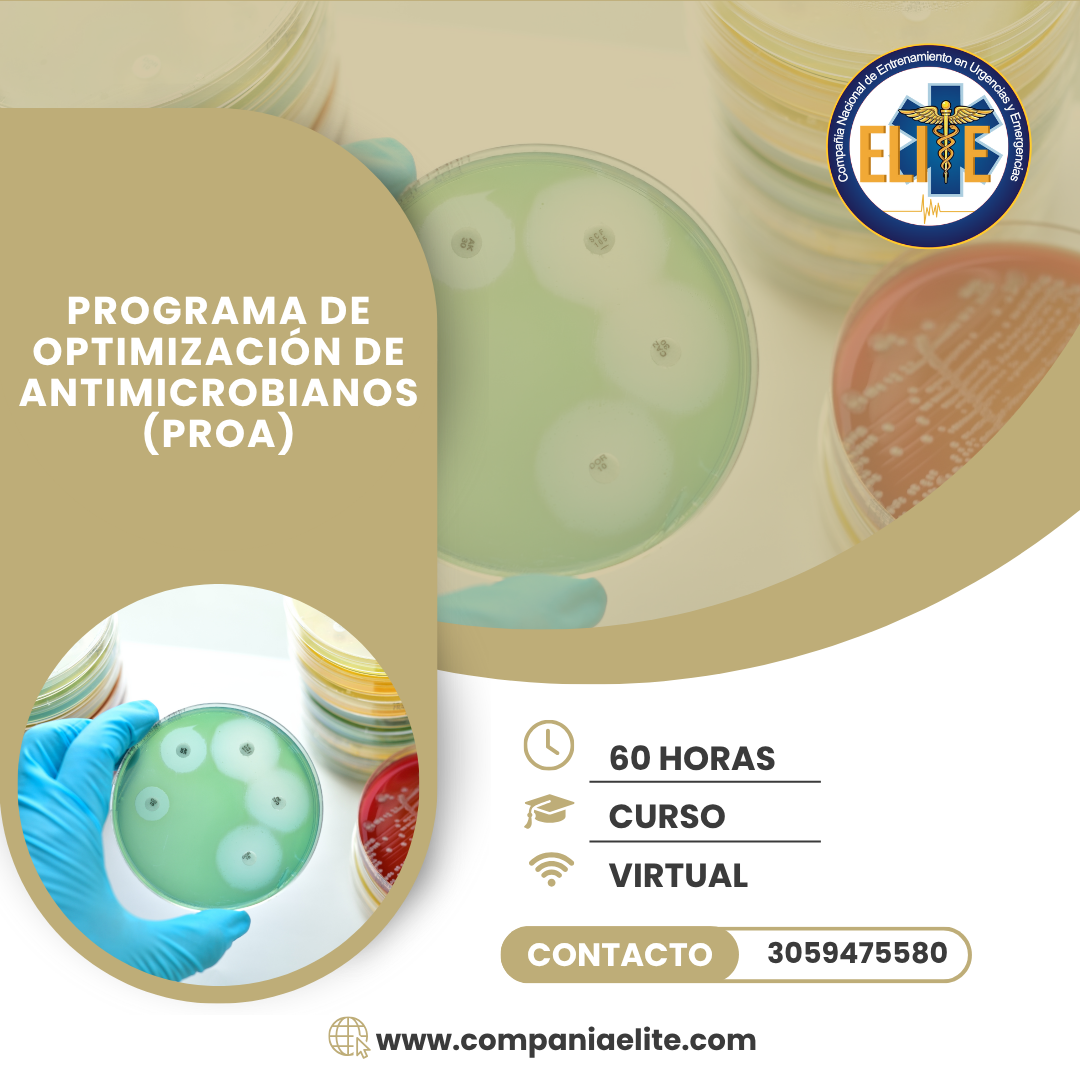
(PROA) PROGRAMA DE OPTIMIZACIÓN DE ANTIMICROBIANOS

5.00
(4.00)
Compañia Élite
103 Cursos • 3010 Estudiantes
5.00
(4.00)
Biografía
Los datos de la biografía están vacíosCursos
IAMII – INSTITUCIONES AMIGAS DE LA MUJER Y LA INFANCIA INTEGRAL
120h
por Compañia Élite
en DIPLOMADOS
AIEPI CLÍNICO – ATENCIÓN INTEGRAL A LAS ENFERMEDADES PREVALENTES DE LA INFANCIA
120h
por Compañia Élite
en DIPLOMADOS
5.00
(1)
ACOMPAÑAMIENTO Y GESTIÓN EN MANEJO DEL DUELO Y PÉRDIDA
48h
por Compañia Élite
en CURSOS BÁSICOS
PAPSIVI – PROGRAMA DE ATENCIÓN PSICOSOCIAL Y SALUD INTEGRAL A VÍCTIMAS
48h
por Compañia Élite
en CURSOS BÁSICOS
AIEPI COMUNITARIO – ATENCIÓN INTEGRAL A LAS ENFERMEDADES PREVALENTES DE LA INFANCIA
120h
por Compañia Élite
en DIPLOMADOS
MANEJO DE PRUEBAS EN PUNTO DE ATENCIÓN (POCT) – POINT-OF CARE TESTING
48h
por Compañia Élite
en CURSOS BÁSICOS
5.00
(1)
ATENCIÓN INTEGRAL EN SALUD A VÍCTIMAS DE VIOLENCIA SEXUAL
48h
por Compañia Élite
en CURSOS BÁSICOS
ATENCIÓN INTEGRAL DE NIÑOS Y NIÑAS MENORES DE 5 AÑOS CON DESNUTRICIÓN AGUDA
120h
por Compañia Élite
en DIPLOMADOS
SEDACIÓN AVANZADA – FUERA DE QUIRÓFANO PARA MÉDICOS NO ANESTESIÓLOGOS
120h
por Compañia Élite
en DIPLOMADOS
PREVENCIÓN Y CONTROL DE INFECCIONES MULTIRRESISTENTES EN AMBIENTE HOSPITALARIO
40h
por Compañia Élite
en CURSOS BÁSICOS
ATENCIÓN EN SALUD CON ENFOQUE DIFERENCIAL PARA POBLACIÓN LGTBIQ+
120h
por Compañia Élite
en DIPLOMADOS
ATENCIÓN, CARACTERIZACIÓN E INCLUSIÓN DE PERSONAS CON DISCAPACIDAD
120h
por Compañia Élite
en DIPLOMADOS
MANEJO DE HERRAMIENTAS MICROSOFT OFFICE “Word – Excel – PowerPoint – Outlook – Access”
110h
por Compañia Élite
en DIPLOMADOS
EXAMEN CLÍNICO PARA LA DETECCIÓN TEMPRANA DE CÁNCER DE MAMA
40h
por Compañia Élite
en CURSOS BÁSICOS
MANEJO DE HIPERTENSIÓN ARTERIAL Y DEL RIESGO CARDIOVASCULAR
40h
por Compañia Élite
en CURSOS BÁSICOS
ATENCIÓN INTEGRAL EN SALUD CON ENFOQUE PSICOSOCIAL A VÍCTIMAS DEL CONFLICTO ARMADO
48h
por Compañia Élite
en CURSOS BÁSICOS